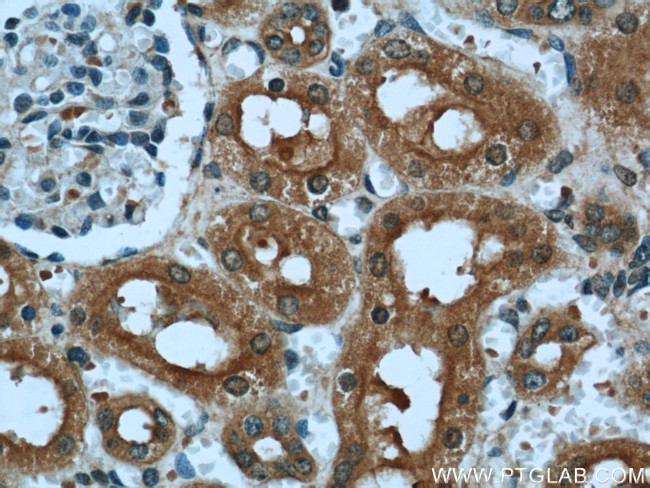
DARC Antibody in Immunohistochemistry (Paraffin) (IHC (P))
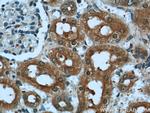
DARC Antibody in Immunohistochemistry (Paraffin) (IHC (P))

Search
Proteintech
DARC Polyclonal Antibody
{{$productOrderCtrl.translations['antibody.pdp.commerceCard.promotion.promotions']}}
{{$productOrderCtrl.translations['antibody.pdp.commerceCard.promotion.viewpromo']}}
{{$productOrderCtrl.translations['antibody.pdp.commerceCard.promotion.promocode']}}: {{promo.promoCode}} {{promo.promoTitle}} {{promo.promoDescription}}. {{$productOrderCtrl.translations['antibody.pdp.commerceCard.promotion.learnmore']}}
产品信息
55185-1-AP
种属反应
宿主/亚型
分类
类型
抗原
偶联物
形式
浓度
规格
纯化类型
保存液
内含物
保存条件
运输条件
产品详细信息
This antibody is specific to CD234.
靶标信息
ACKR1 or DARC is an atypical chemokine receptor that controls chemokine levels and localization via high-affinity chemokine binding that is uncoupled from classic ligand-driven signal transduction cascades resulting instead in chemokine sequestration, degradation, or transcytosis. ACKR1 is also known as an interceptor (internalizing receptor) or chemokine-scavenging receptor or chemokine decoy receptor. It has a promiscuous chemokine-binding profile by interacting with inflammatory chemokines of both the CXC and the CC subfamilies but not with homeostatic chemokines. ACKR1 also acts as a receptor for chemokines including CCL2, CCL5, CCL7, CCL11, CCL13, CCL14, CCL17, CXCL5, CXCL6, IL8/CXCL8, CXCL11, GRO, RANTES, MCP-1, TARC and for the malaria parasites P.vivax and P.knowlesi.
仅用于科研。不用于诊断过程。未经明确授权不得转售。
篇参考文献 (0)
生物信息学
蛋白别名: Atypical chemokine receptor 1; bloodgroup FY protein; CD234; CD234 antigen; CTA-134P22.3; Duffy Antigen; Duffy antigen chemokine receptor; Duffy antigen receptor for chemokines; Duffy antigen/chemokine receptor; Duffy blood group antigen; Duffy blood group system protein; Duffy blood group, chemokine receptor; Fy Antigen; Fy glycoprotein; FYDuffy blood group; Glycoprotein D; GPDWBCQ1; GpFy; HGNC:4035; OTTHUMP00000060081; Plasmodium vivax receptor; solute carrier family 29 member 1 (augustine blood group); unnamed protein product
基因别名: ACKR1; CCBP1; CD234; DARC; DARC/ACKR1; Dfy; FY; GPD; GpFy; WBCQ1
UniProt ID: (Human) Q16570
Entrez Gene ID: (Human) 2532